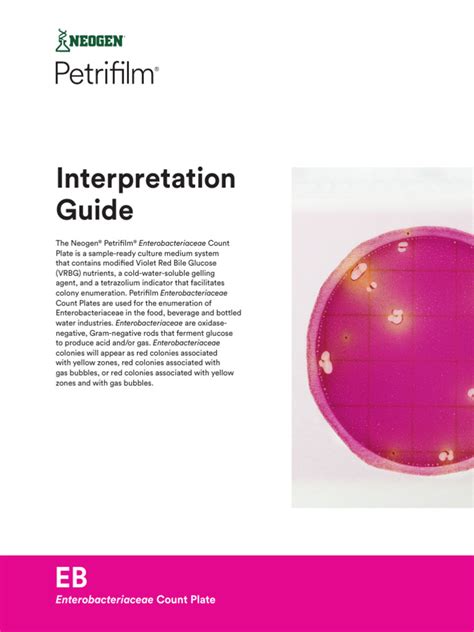

Petrifilm AC: Your Ultimate Interpretation Guide
Petrifilm AC: Your Ultimate Interpretation Guide
Hey guys! Ever wondered how to accurately interpret those Petrifilm Aerobic Count (AC) plates? Well, you’re in the right place! This guide will walk you through everything you need to know about Petrifilm AC interpretation, ensuring you get reliable and accurate results every time. Let’s dive in!
Table of Contents
What is Petrifilm AC?
Petrifilm Aerobic Count (AC) plates are ready-to-use culture media systems designed for the enumeration of aerobic bacteria in the food and beverage industries. These plates provide a convenient and efficient method for assessing the overall microbial quality of products. Unlike traditional agar plates, Petrifilm AC plates eliminate the need for manual preparation, sterilization, and washing, which saves time and reduces the risk of contamination. Each plate contains nutrients, a cold-water-soluble gelling agent, and an indicator dye that facilitates colony counting.
The advantages of using Petrifilm AC plates are numerous. First, they offer significant time savings in laboratory workflows. Traditional methods can take hours to prepare, whereas Petrifilm plates are ready to use straight out of the package. Second, they reduce the potential for errors associated with manual media preparation. The consistent formulation of Petrifilm plates ensures reliable and reproducible results across different batches and laboratories. Third, they minimize the risk of contamination, as the plates are sealed and self-contained, reducing exposure to environmental contaminants. Finally, Petrifilm plates require less storage space compared to bulky agar plates and bottles of media, making them an efficient option for laboratories with limited space. Petrifilm AC plates are widely recognized and validated by regulatory agencies and industry organizations, making them a trusted tool for quality control and food safety monitoring.
Key Components of a Petrifilm AC Plate
Understanding the key components of a Petrifilm AC plate is crucial for accurate interpretation. Each plate consists of a top film and a bottom film, with a layer of dehydrated culture medium containing nutrients, a gelling agent, and a tetrazolium indicator dye sandwiched between them. The nutrients support the growth of aerobic bacteria, while the gelling agent solidifies the medium after incubation. The tetrazolium dye is a redox indicator that changes color in the presence of metabolically active bacteria, making the colonies visible and easy to count. When bacteria grow on the plate, they reduce the tetrazolium dye, causing the formation of red or pink colonies. The intensity of the color depends on the metabolic activity of the bacteria and the duration of incubation.
Additionally, some Petrifilm AC plates include a foam barrier that helps contain the sample and prevent leakage. This feature is particularly useful when analyzing liquid samples or performing dilutions directly on the plate. The top film serves as a protective layer and also provides a surface for writing sample information, such as the date, sample ID, and dilution factor. The bottom film is typically transparent, allowing for easy visualization of the colonies. It is essential to handle Petrifilm AC plates with care to avoid damage or contamination. Always store the plates in a cool, dry place away from direct sunlight and extreme temperatures. Before use, check the expiration date and ensure that the packaging is intact. Any signs of damage or discoloration may indicate that the plate has been compromised and should not be used. Proper handling and storage practices are essential for maintaining the integrity of the plates and ensuring accurate and reliable results.
Step-by-Step Guide to Interpreting Petrifilm AC Results
Follow this step-by-step guide to accurately interpret your Petrifilm AC results:
1. Preparation:
First, make sure you have properly prepared your Petrifilm AC plates. This includes proper sample dilution and plating techniques. Accurate dilution is crucial for obtaining countable plates. If the bacterial load in your sample is too high, the colonies may be too numerous to count (TNTC), leading to inaccurate results. Similarly, if the bacterial load is too low, you may not detect any colonies, even if bacteria are present. Proper plating techniques involve evenly distributing the diluted sample onto the Petrifilm AC plate and allowing it to gel completely before incubation. Avoid creating air bubbles or uneven distribution of the sample, as this can affect colony formation and counting.
2. Incubation:
Next, incubate the plates according to the manufacturer’s instructions (usually 48 hours at 35°C). Consistent incubation conditions are essential for reliable results. Variations in temperature or incubation time can affect the growth rate and colony morphology of bacteria, leading to inaccurate counts. Use a calibrated incubator and monitor the temperature regularly to ensure it remains within the recommended range. Avoid stacking the plates too tightly, as this can restrict air circulation and affect temperature uniformity. Also, be sure to orient the plates correctly in the incubator to prevent condensation from dripping onto the agar surface.
3. Colony Counting:
Colony counting is the most critical step. Count all the red or pink colonies, as these indicate aerobic bacteria. Use a colony counter or a magnifying glass for better visibility. Differentiate between colonies and artifacts such as air bubbles or undissolved particles. Colonies are typically round, well-defined, and may have a slightly raised appearance. Artifacts, on the other hand, are usually irregular in shape and lack the distinct characteristics of bacterial colonies. If you are unsure whether a particular spot is a colony or an artifact, examine it closely under magnification. Colonies will often exhibit a textured surface or a slight halo around them, while artifacts will appear smooth and featureless.
4. Accounting for Large Colonies:
For large colonies that may be difficult to count individually, estimate the count by dividing the area covered by the colony into smaller, manageable sections and counting the number of colonies in each section. Then, multiply the average count per section by the total number of sections to estimate the total count. This method is particularly useful when dealing with spreading colonies or confluent growth. However, it is important to use caution and avoid overestimation. If possible, dilute the sample further and replate to obtain countable plates with well-separated colonies.
5. Correcting for Dilution:
Finally, correct for the dilution factor to determine the number of colony-forming units per milliliter (CFU/mL) or gram (CFU/g) of the original sample. Multiply the colony count by the inverse of the dilution factor. For example, if you counted 50 colonies on a plate that was inoculated with 0.1 mL of a 1:100 dilution, the calculation would be 50 colonies x 100 (dilution factor) x 10 (to account for the 0.1 mL inoculum) = 50,000 CFU/mL. Ensure that you use the correct units and report the results in a clear and concise manner. Always include the dilution factor in your report to allow others to verify your calculations and interpret your results accurately.
Identifying Common Issues
Let’s talk about identifying common issues you might encounter during Petrifilm AC interpretation. One common problem is distinguishing between colonies and artifacts. Food particles, air bubbles, or undissolved media components can sometimes mimic the appearance of colonies, leading to overestimation of bacterial counts. To avoid this, carefully examine each spot under magnification and look for the characteristic features of bacterial colonies, such as a well-defined shape, raised appearance, and textured surface. If you are unsure whether a particular spot is a colony or an artifact, it is best to err on the side of caution and exclude it from the count.
Another issue is dealing with overcrowded plates. When the bacterial load is too high, colonies may merge together, making it difficult to count them accurately. In such cases, it is necessary to dilute the sample further and replate to obtain countable plates with well-separated colonies. If dilution is not possible, you can try estimating the count by dividing the plate into smaller sections and counting the number of colonies in each section, as described earlier. However, this method is less accurate and should only be used as a last resort.
Tips for Accurate Interpretation
Here are some tips for accurate interpretation :
- Use a Colony Counter: A colony counter provides consistent lighting and magnification, which helps to reduce errors in colony counting.
- Mark Colonies: Use a marker to mark each colony as you count it to avoid double-counting.
- Take Breaks: If you are counting a large number of plates, take frequent breaks to avoid eye strain and fatigue.
- Compare with Controls: Always compare your results with positive and negative controls to ensure the validity of your results.
Troubleshooting Common Problems
Troubleshooting is a crucial part of the interpretation process. If you encounter issues such as non-typical colonies or unclear results, consult the Petrifilm AC interpretation guide or contact technical support for assistance. Non-typical colonies may indicate the presence of specific types of bacteria or contaminants. In such cases, further testing may be necessary to identify the organisms and determine their significance. Unclear results may be due to various factors, such as improper incubation conditions, contaminated plates, or errors in sample preparation. By carefully reviewing your procedures and consulting with experts, you can identify and resolve these issues, ensuring accurate and reliable results.
Conclusion
Alright, folks! Mastering Petrifilm AC interpretation is key to ensuring food safety and quality. By understanding the components of the plates, following the step-by-step guide, and troubleshooting common issues, you can achieve accurate and reliable results. Happy counting!